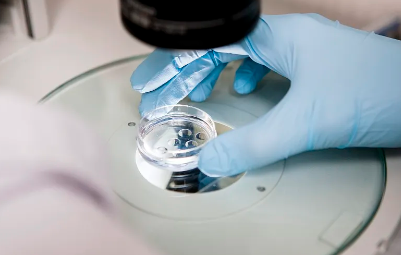
image.png

湖北原代干細(xì)胞技術(shù)哪家領(lǐng)先?臨床應(yīng)用前景如何?
2024-10-24 11:46:17 來源: 小編 咨詢醫(yī)生
本文將詳細(xì)介紹湖北地區(qū)在原代干細(xì)胞技術(shù)領(lǐng)域的領(lǐng)先企業(yè)和研究機(jī)構(gòu),以及這些技術(shù)的臨床應(yīng)用前景。
湖北原代干細(xì)胞技術(shù)領(lǐng)先企業(yè)及研究機(jī)構(gòu)
1.武漢大學(xué)
武漢大學(xué)是我國著名的高等學(xué)府,其在干細(xì)胞研究領(lǐng)域有著舉足輕重的地位。武漢大學(xué)醫(yī)學(xué)部的研究團(tuán)隊(duì)在原代干細(xì)胞技術(shù)方面取得了顯著成果,尤其在干細(xì)胞定向分化、組織工程等領(lǐng)域取得了突破性進(jìn)展。
2.華中科技大學(xué)
華中科技大學(xué)同濟(jì)醫(yī)學(xué)院也是我國干細(xì)胞研究的重要基地。該校的研究團(tuán)隊(duì)在原代干細(xì)胞技術(shù)領(lǐng)域有著豐富的經(jīng)驗(yàn),成功研發(fā)出多種干細(xì)胞治療產(chǎn)品,并在臨床應(yīng)用中取得了良好的效果。
3.漢口大學(xué)生命科學(xué)學(xué)院
漢口大學(xué)生命科學(xué)學(xué)院的研究團(tuán)隊(duì)在原代干細(xì)胞技術(shù)領(lǐng)域有著較高的人氣。該學(xué)院利用原代干細(xì)胞技術(shù)成功制備出多種組織器官,為臨床應(yīng)用提供了有力支持。
湖北原代干細(xì)胞技術(shù)臨床應(yīng)用前景
1.神經(jīng)系統(tǒng)疾病
原代干細(xì)胞技術(shù)受益。在神經(jīng)系統(tǒng)疾病治療方面,湖北地區(qū)的原代干細(xì)胞技術(shù)已經(jīng)成功應(yīng)用于帕金森病、阿爾茨海默病等疾病的治療。通過將原代干細(xì)胞定向分化為神經(jīng)元,修復(fù)受損的神經(jīng)細(xì)胞,為患者帶來福音。
2.心血管疾病
心血管疾病是導(dǎo)致人類死亡的主要原因之一。湖北地區(qū)的原代干細(xì)胞技術(shù)在心血管疾病治療方面取得了顯著成果。研究人員通過將原代干細(xì)胞定向分化為心肌細(xì)胞,修復(fù)受損的心肌,提高心臟功能。
3.骨科疾病
在骨科疾病治療方面,原代干細(xì)胞技術(shù)同樣具有廣泛的應(yīng)用前景。湖北地區(qū)的科研團(tuán)隊(duì)成功利用原代干細(xì)胞技術(shù)修復(fù)骨折、軟骨損傷等疾病,為患者減輕痛苦。
4.腫瘤治療
原代干細(xì)胞技術(shù)在腫瘤治療領(lǐng)域也具有重要作用。湖北地區(qū)的科研團(tuán)隊(duì)通過將原代干細(xì)胞定向分化為免疫細(xì)胞,提高患者免疫力,抑制腫瘤生長(zhǎng)。
總之,湖北原代干細(xì)胞技術(shù)在國內(nèi)處于領(lǐng)先地位,臨床應(yīng)用前景廣闊。隨著科研團(tuán)隊(duì)在原代干細(xì)胞技術(shù)領(lǐng)域的不斷探索,未來將有更多患者受益于這一技術(shù)。同時(shí),湖北地區(qū)也將繼續(xù)加大投入,推動(dòng)原代干細(xì)胞技術(shù)的發(fā)展,為我國生物醫(yī)學(xué)領(lǐng)域作出更大貢獻(xiàn)。
- 2024-10-11干細(xì)胞培植皮膚技術(shù)成熟嗎?效果可以持續(xù)多久?
- 2024-11-01溫嶺有哪些值得信賴的干細(xì)胞捐贈(zèng)機(jī)構(gòu)?怎樣選擇?
- 2024-10-12北京地區(qū)干細(xì)胞研究進(jìn)展怎樣?有哪些成果?
- 2024-10-15干細(xì)胞的分類,干細(xì)胞的特點(diǎn)有哪些
- 2024-09-27貝拉國際腫瘤醫(yī)院是正規(guī)醫(yī)院?jiǎn)?/a>
- 2024-11-04自體干細(xì)胞除皺價(jià)格差異因素有哪些?怎樣判斷性價(jià)比?
- 2024-09-03哪兒打干細(xì)胞效果好,干細(xì)胞機(jī)構(gòu)權(quán)威排名
- 2024-09-27貝拉國際細(xì)胞醫(yī)療怎么樣
- 2024-09-10淋巴瘤干細(xì)胞移植費(fèi)用走醫(yī)保嗎
- 2024-08-06間充質(zhì)干細(xì)胞治療,間充質(zhì)干細(xì)胞治療的原理
- 2024-07-22牙髓干細(xì)胞治療牙周炎,牙髓干細(xì)胞治療牙周炎效果好嗎
- 2024-09-16婕斯干細(xì)胞護(hù)膚品價(jià)格,婕斯干細(xì)胞產(chǎn)品怎么樣
- 2024-09-17干細(xì)胞采集的詳細(xì)過程是怎樣的,提取流程全解讀
- 2024-09-16白血病干細(xì)胞移植費(fèi)用多少錢,醫(yī)保能報(bào)銷嗎
- 2024-09-01干細(xì)胞肺癌治療臨床效果評(píng)估
- 2024-10-04干細(xì)胞與免疫細(xì)胞作用揭秘,它們?nèi)绾螀f(xié)同工作
- 2024-10-08植物干細(xì)胞增殖調(diào)控機(jī)構(gòu)如何運(yùn)作?有哪些研究成果?
- 2024-08-09廣州干細(xì)胞醫(yī)治偏癱的過程
